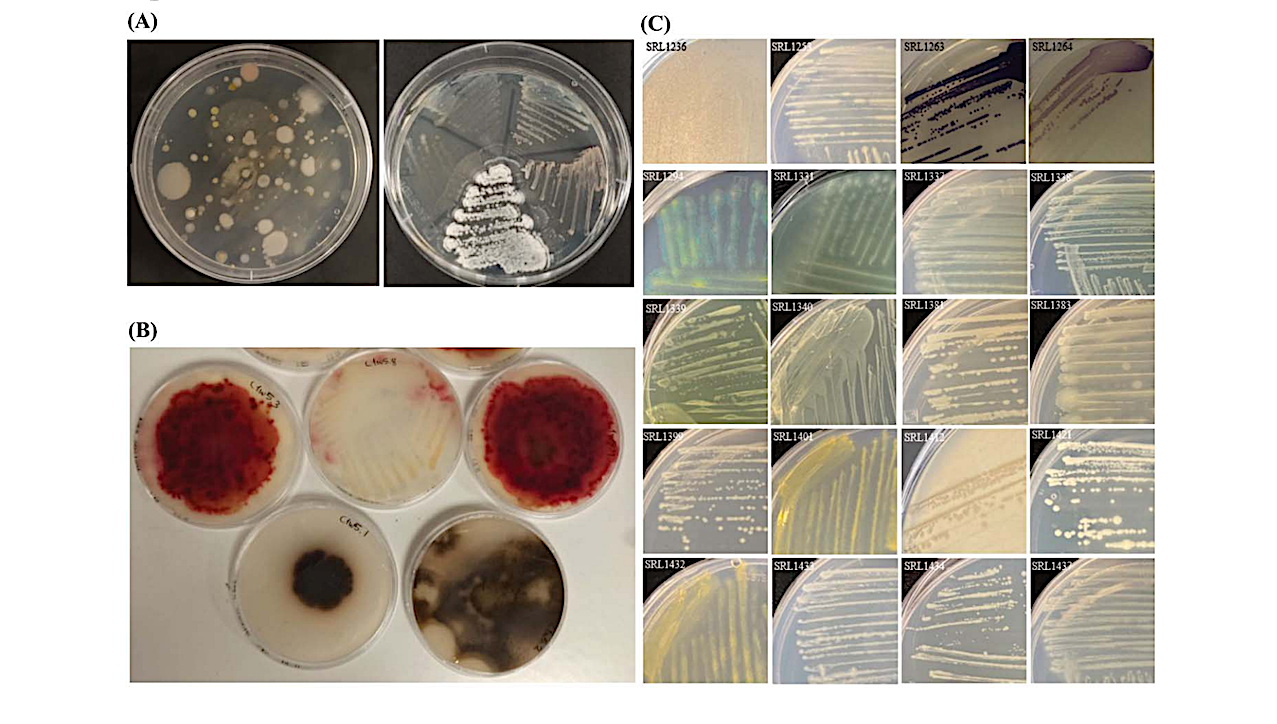
A Thousand Meters Deep: Vertical Profiling of the Subterranean Microbiome of Gourgouthakas Cave

Selected pictures of microbial diversity of Gourgouthakas isolated bacteria. (A-B) Initial screenings of sample material prior to purecultures. (C) A “color palette” of isolated microbes from the collection of Gourgouthakas cave. Variaty of colors from yellow, purple and bioiridescent colonies. — biorxiv.org
Introduction: Caves represent unique, nutrient-limited windows into the deep biosphere, yet the microbiology of the deep terrestrial subsurface remains remarkably under-explored. In this work, we took advantage of a rare expedition into Gourgouthakas Cave (Crete, Greece), one of the deepest vertical systems in the world, which had remained untouched by humans for 19 years.
Methods: We performed a high-resolution vertical profiling of the microbiome by sampling rock surfaces across nine different depths down to 1,100 meters. Through extensive cultivation using various media and temperatures, we established a biobank of 820 bacterial isolates.
Results: Taxonomic identification of a 362-isolate subset revealed a diverse community spanning 25 genera and 4 phyla, dominated by Pseudomonas, Bacillus, and Stenotrophomonas. Beyond characterizing diversity, we explored the biotechnological potential of these subterranean microbes against major agricultural threats. Screening 70 representative isolates against six key pathogens, including Ralstonia solanacearum, Verticillium dahliae, and Phytophthora nicotianae, uncovered a significant group of strains with potent antagonistic activity, particularly with-in the Pseudomonas and Brevibacillus groups.
Genomic sequencing of cave-derived Actinobacteria (Streptomyces and Nocardiopsis isolates) further highlighted this potential, revealing 142 bio-synthetic gene clusters (BGCs); notably, over half of these showed little to no similarity to known clusters, suggesting a hidden reservoir of novel secondary metabolites. Finally, ex vivo trials showed that the Pseudomonas sp. SRL917 isolate significantly reduced Botrytis cinerea infections on tomato leaves, even surpassing the performance of a commercial biocontrol agent.
Discussion: Collectively, our results demonstrate that deep karstic systems are not just geological wonders but vital hotspots for microbial innovation with tangible applications for sustainable agriculture.

Gourgouthakas cave microbiome sampling and topography. (A) Samping sites along the cave with the respective picture of the substrate material (Photos S. Paragkamian). (B) The area Atzinolakas with the complex karst and faults (Photo M. Vaxevanopoulos). (C) One of the main pits of the cave, named Guillaume, at -450 m (Photo Y. Sotiriadis). (D) First siphon of the karstic aquifer at -678m (Photo Y. Sotiriadis). (E) Pit “Samuel” at -950m with constant flow of water (Photo M. Vaxevanopoulos). (F) Last siphon at -1100 m depth (Photo M. Vaxevanopoulos) — biorxiv.org
A Thousand Meters Deep: Vertical Profiling of the Subterranean Microbiome of Gourgouthakas Cave, biorxiv.org (open access)
Astrobiology, Away Team, Spelunking, extremophile,